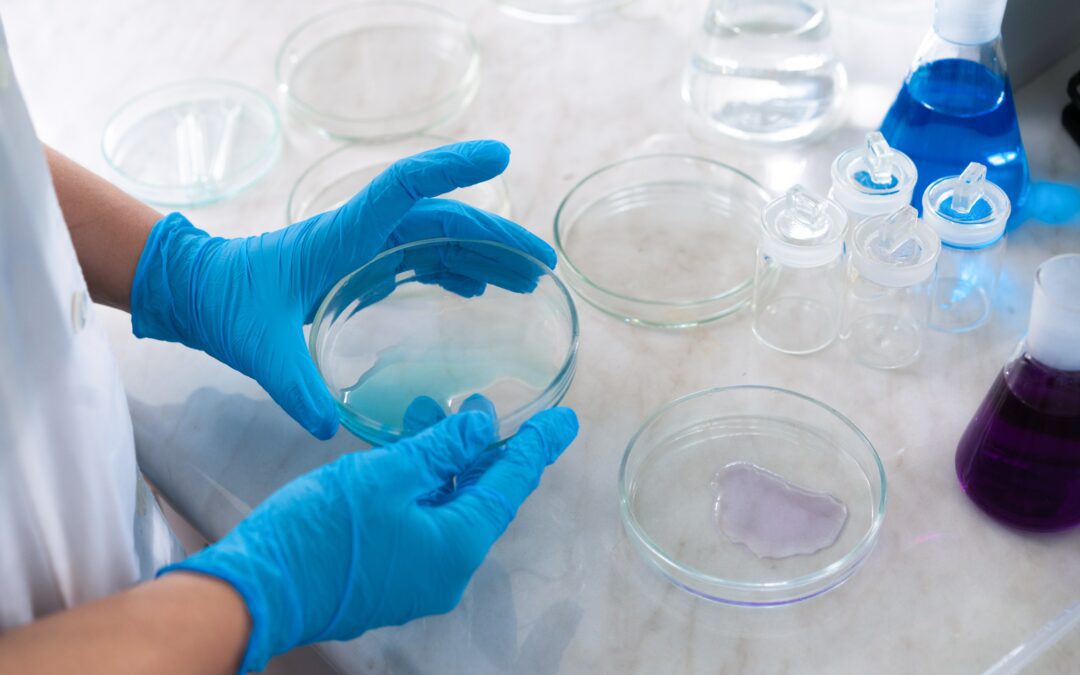
E’ italiana la prima sonda cerca-tumore testata su pazienti

27 Set, 2023 | Attualità, Innovazione
ClimaMeter è nata da un gruppo di ricerca internazionale al quale l’Italia partecipa con l’Istituto Nazionale di Geofisica e Vulcanologia, in collaborazione con il Centre National de la Recherche Scientifique francese, l’Università svedese di Uppsala...

26 Set, 2023 | Ambiente, Innovazione
Il confronto sul benessere animale è in Italia particolarmente sentito dall’evidenza di una sempre maggior attenzione dei consumatori ai temi ambientali ed etici, e dall’evidenza che esiste una chiara correlazione tra benessere animale, qualità dei prodotti, rispetto...

25 Set, 2023 | Innovazione
È stata sviluppata dall’Università di Pisa per fornire informazioni su regolamenti e funzionamento dell’Ateneo in qualsiasi lingua. Ma con il sardo non va molto d’accordo Immaginiamo quanti studenti arrivano ogni anno all’Università di Pisa e...

21 Set, 2023 | Attualità, Eventi, Innovazione
A Telepress Andrea Salvetti, uno dei fondatori, racconta come sia nata la manifestazione (22/23/24 settembre) e come quest’anno possa accogliere addirittura il guru dell’informatica Federico Faggin. Ancora prima della pandemia l’idea di creare un...

13 Set, 2023 | Attualità, Eventi, Innovazione
Il capoluogo ligure ospita la manifestazione dal 21 al 26 settembre. Più di mille le imbarcazioni che verranno esposte al Waterfront di Levante. C’è la mano di un genovese d.o.c. come Renzo Piano (che pure risiede in Francia) dietro al progetto del Waterfront...

3 Set, 2023 | Innovazione
L’innovativo strumento è stato sviluppato dall’Istituto Nazionale di Fisica Nucleare e dall’Università Sapienza di Roma, coordinato da Emilio Bertani della Divisione di Chirurgia dell’apparato digerente e Direttore dell’Unità di Chirurgia dei tumori neuroendocrini...